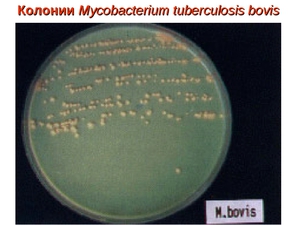
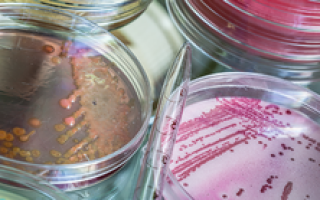

Способность бактерий туберкулеза быстро развивать устойчивость к лекарственным препаратам – одна из причин широкого распространения инфекции, снижения эффективности и удорожания лечения.

Почему туберкулезная палочка приобретает устойчивость?
Лекарственно-устойчивый туберкулез формируется тогда, когда из-за спонтанных мутаций появляются бактерии, нечувствительные к лекарству, или когда не удается поддерживать необходимую концентрацию препарата в крови. В результате гибнут не все возбудители, менее чувствительные выживают. Если применяется несколько антибиотиков, то устойчивые бактерии могут быть уничтожены ими.
При монотерапии или при неправильно подобранной схеме выжившие палочки размножаются, и их потомки наследуют свойство резистентности к данному лекарству. Невосприимчивость туберкулезной палочки закрепляется генетически. Так формируется лекарственная устойчивость микобактерий туберкулеза.
Формированию устойчивости способствуют некоторые клинические ситуации. Знание этих условий необходимо для предотвращения перехода заболевания в устойчивую форму:
- недостаточная продолжительность курса лечения,
- пропуски в приеме препаратов,
использование дозы лекарства, ниже рекомендованной,
- использование некачественных лекарственных средств,
- назначение сочетаний химиопрепаратов без проверки чувствительности к ним (если один из препаратов неэффективен, вероятность формирования резистентности к другому велика),
- назначение нерациональных схем,
- использование противотуберкулезных антибиотиков с широким спектром антимикробной активности (фторхинолонов) для лечения других бактериальных инфекций (например, пневмонии) с нераспознанным туберкулезом,
- перекрестная резистентность – если появляется резистентность к одному химиопрепарату может возникнуть резистентность и к другому из того же класса.
Стоит помнить, что одна из основных причин развития лекарственно-устойчивого туберкулеза – недостаточная приверженность терапии.
Больные, достигая положительных результатов терапии, часто перестают адекватно оценивать серьезность ситуации и начинают пропускать прием лекарств, а то и вовсе бросают лечение. Если к этому моменту не наступило выздоровление, через некоторое время заболевание снова начинает прогрессировать, но уже в виде устойчивой формы туберкулеза. Есть и другие причины формирования устойчивости (врачебные ошибки, недочеты в организации лечебного процесса, отсутствие лекарств).
Особую значимость в появлении лекарственно устойчивого туберкулеза имеет заболеваемость в местах лишения свободы. В появлении и распространении форм туберкулеза, устойчивого к лечению, среди лиц из МЛС участвуют следующие факторы:
высокая скученность зараженных людей,
- пребывание социально неадаптированных лиц с высоким уровнем заболеваемости совместно с относительно благополучными заключенными,
- недостаточное обеспечение медикаментами,
- отсутствие преемственности в лечении (некоторая часть туберкулезных больных не обращаются в диспансеры после освобождения и не лечится).
Эта группа людей служит постоянным источником устойчивых штаммов возбудителя. В результате, излечение вновь заразившихся больных становится все более проблематичным, растет уровень заболеваемости, количество тяжелых форм и летальных исходов.
Важно! Заражение человека микобактерией, устойчивой к препаратам, ведет к заболеванию первично резистентным туберкулезом, который даже при выявлении на ранних стадиях очень плохо поддается лечению.
Виды лекарственно устойчивого туберкулеза и их терапия
Туберкулезная палочка может приобретать резистентность к нескольким химиопрепаратам. Чем более устойчива палочка, тем сложнее подобрать схему лечения. В зависимости от того, к каким препаратам возбудитель нечувствителен, выделяется 3 формы лекарственно-устойчивого туберкулеза:
Туберкулез с множественной лекарственной устойчивостью (МЛУ-ТБ). Эта форма диагностируется при устойчивости микобактерии к двум самым сильным противотуберкулезным химиопрепаратам первой линии – Изониазиду и Рифампицину, независимо от наличия или отсутствия устойчивости к другим препаратам этой группы.
- Туберкулез с широкой лекарственной устойчивостью (ШЛУ-ТБ). Она диагностируется при устойчивости к Изониазиду, Рифампицину и другим препаратам – любому из фторхинолонов и любому из инъекционных антибиотиков третьей линии (Канамицину, Амикацину или Капреомицину).
- Абсолютно устойчивый туберкулез. Этот термин не является официально признанным медицинским сообществом, но он хорошо отражает ситуацию – микобактерия резистентна ко всем химиопрепаратам, тестирование на лекарственную чувствительность (ТЛЧ) к которым проводилось.

Клинически эта форма болезни в момент постановки диагноза ничем не отличается, разница – в ответе на лечение. Заподозрить лекарственно-устойчивый туберкулез можно при отсутствии эффекта от терапии в течение 4–6 месяцев, при прогрессировании процесса на фоне приема лекарств, при продолжающемся бактериовыделении свыше 4 месяцев.
В идеале, тестирование на лекарственную чувствительность должно проводиться всем больным при установлении диагноза, по крайней мере, к основным химиопрепаратам. Организационно это не всегда возможно, поэтому определение чувствительности должно проводиться как минимум больным из групп риска:
больным, ранее получавшим лечение по поводу туберкулеза,
- ВИЧ-инфицированным,
- работникам медицинских учреждений,
- пациентам, бывшим в контакте с больными устойчивыми формами или с умершим от МЛУ-ТБ,
- больным, продолжающим выделять микобактерию после 4 месяцев лечения,
- освободившиеся из МЛС.
Лечение больных с МЛУ–ТБ проводится в соответствии со стандартными схемами. В разработке стратегии лечения должны учитываться не только аспекты подбора препаратов и режима дозирования.
Важно! Для успешного лечения необходимо уделять внимание мотивации больных к соблюдению режима приема лекарств и выдерживанию необходимой продолжительности курса.
Основные принципы терапии лекарственно устойчивого туберкулеза:
- назначается одновременно 5 химиопрепаратов с доказанной чувствительностью к выделенному штамму, а при эмпирическом лечении или при тяжелых формах поражения – и более пяти препаратов,
- применяют максимальные дозы,
инъекционные антибиотики продолжают вводить еще 6 месяцев после прекращения бактериовыделения,
- после получения отрицательного посева мокроты лечение продолжается еще 18 месяцев, общая продолжительность составляет около 2 лет,
- прием лекарств производится под контролем медицинского персонала 6 дней в неделю 2–3 раза (в зависимости от схемы) в день,
- обязательно получение информированного согласия на лечение,
- учет этих больных в единой базе данных.
Количество больных туберкулезом во всем мире постоянно увеличивается, в том числе и из-за роста числа больных, инфицированных устойчивыми штаммами. Кроме того, заболеваемость туберкулезом имеет довольно выраженный социальный характер. Ему подвержены в большей степени как раз именно те люди, лечение которых сложнее контролировать. Знание этих фактов, понимание механизмов развития устойчивости и строгое следование рекомендациям, разработанным научным сообществом – инструменты, дающие надежду на обретение контроля над этой болезнью.
Определение лекарственной резистентности микобактерий туберкулеза
Чувствительными к данному препарату считаются те штаммы микобактерий, на которые этот препарат в критической концентрации (критерий устойчивости) оказывает бактерицидное или бактериостатическое действие.
Устойчивость (резистентность) определяется как снижение чувствительности до такой степени, что данный штамм микобактерий способен размножаться при воздействии на него препарата в критической или более высокой концентрации.
Наряду с понятиями чувствительности и устойчивости к противотуберкулезным препаратам в настоящее время используются также термины, определяющие количественную и качественную стороны лекарственной устойчивости.
Характеристика лекарственно-устойчивого туберкулеза
Приобретенная (вторичная) резистентность — это такие случаи туберкулеза, когда штаммы МБТ превращаются из чувствительных в устойчивые фенотипы в процессе или после курса химиотерапии. Неэффективная химиотерапия туберкулеза способствует селекции лекарственно-устойчивых мутантов МБТ.
Наличие приобретенной резистентности подозревается у больных, имеющих в анамнезе указания на лечение противотуберкулезными препаратами в течение 1 мес или более, при этом первоначально было известно, что в начале терапии данный штамм МБТ был чувствителен к противотуберкулезным препаратам.
Первичная резистентность. В некоторых случаях у больных при начальном обследовании выявляются штаммы МБТ, имеющие выраженную резистентность к одному или нескольким противотуберкулезным препаратам.
Первичная резистентность имеет место, когда человек инфицирован МБТ, уже будучи резистентными к одному или большему количеству противотуберкулезных препаратов.
Комбинированная резистентность. Определение, принятое Всемирной организацией здравоохранения, суммирует первичную и приобретенную резистентность для определения ее распространенности.
Монорезистентность. Штаммы МБТ резистентны только к одному из пяти противотуберкулезных препаратов первого ряда (рифампицин, изониазид, этамбутол, пиразинамид, стрептомицин).
Мультирезистентные микобактерии туберкулеза, или мультирезистентный туберкулез (МРТ) — наиболее опасная форма бактериальной резистентности в настоящее время.
МРТ вызывает серьезную озабоченность при борьбе с туберкулезом во многих странах. Начиная с 90-х г. прошлого века отмечено несколько вспышек МРТ в различных регионах мира как следствие неправильного использования противотуберкулезных препаратов.
Обычно МРТ возникает при хроническом туберкулезе, отсутствии эффекта от стандартной схемы химиотерапии, предложенной ВОЗ, или других схем лечения и составляет существенную долю больных туберкулезом с приобретенной резистентностью.
Для различных препаратов установлена определенная концентрация (критическая), имеющая клиническое значение, при которой еще наблюдается размножение чувствительных к этому препарату микобактерий.
Для определения лекарственной устойчивости микобактерий наиболее распространенным является метод абсолютных концентраций на плотной яичной питательной среде Левенштейна- Йенсена.
Лекарственно-устойчивые микроорганизмы способны размножаться при таком содержании препарата в среде, которое оказывает на чувствительные особи бактериостатическое или бактерицидное воздействие.
Геномный анализ чувствительности МБТ к препаратам. Идентифицированы генетические мутантные локусы, обусловившие резистентность к изониазиду, рифампицину, этамбутолу, стрептомицину и фторхинолонам.
Основанные на этой методологии молекулярно-биологические методы постоянно совершенствуются и внедряются в практику, обеспечивая быструю идентификацию лекарственной чувствительности клинических штаммов МБТ.
В первые годы применения антибиотиков и химиопре-паратов отдельные исследователи высказывали суждение относительно нецелесообразности определения лекарственной устойчивости микобактерий туберкулеза в повседневной практике. Их мнение основывалось на том, что результаты лабораторного исследования не отражают истинного состояния устойчивости возбудителя в организме больного. Едва ли, однако, можно согласиться с предложением выразителей крайней точки зрения целиком ограничить бактериологические исследования при туберкулезе только лишь поисками возбудителя болезни методом бактериоскопии и посева, не прибегая к определению лекарственной устойчивости микобактерии туберкулеза. Это противоречит результатам многочисленных наблюдений, приведенных в монографии Н. М. Рудого, а также результатам его собственных исследований.
Разумеется, метод определения лекарственной устойчивости микобактерий туберкулеза надо не только совершенствовать, но и унифицировать. Необходимо повсеместно пользоваться наиболее точным методом исследования и оценивать данные, полученные этим методом, правильными критериями.
Вопрос о критериях резистентности является основным во всей проблеме лекарственной устойчивости. Современные представления указывают на необходимость выделять три критерия устойчивости возбудителя туберкулеза к каждому из препаратов, обладающих туберкулостатическим действием.
Первый — критерий естественной резистентности возбудителя. Речь в данном случае идет о максимальной концентрации препарата в питательной среде, при которой еще растут так называемые дикие штаммы, т. е. микобактерии туберкулеза, еще не контактировавшие с данным туберкулостатическим средством.
Второй критерий, который называют критерием биологической или бактериологической резистентности, соответствует цифрам, превышающим границу естественной резистентности возбудителя, так как она является приобретенной вследствие контакта его с химиопрепаратом или антибиотиком.
Наконец, третий — клинический критерии устойчивости. В клинической практике важно знать, при какой степени устойчивости микобактерий туберкулеза in vitro уже не достигается терапевтический эффект при продолжении лечения больного данным лекарственным средством. Этот критерий (в отличие от двух первых) зависит от многих факторов: характера локального процесса, распределения препарата в организме больного, концентрации его в крови и в участках специфического поражения, где вегетирует возбудитель, особенностей биохимизма этих участков и других известных и пока еще не выясненных причин. Однако причины, остающиеся неизвестными, не препятствовали возможности установления этого критерия, так как с этой целью был использован метод клинико-бактериологических параллелей.
К настоящему времени имеется большое число исследований, посвященных проблеме лекарственной устойчивости микобактерий туберкулеза, в которых показано отрицательное влияние ее на исходы туберкулезного процесса. Отмечающееся в последние годы нарастание удельного веса больных хроническим алкоголизмом среди контингентов больных активным туберкулезом легких определяет необходимость изучения всех факторов, ограничивающих эффективность химиотерапии при сочетании двух названных заболеваний, в том числе лекарственной резистентности возбудителя туберкулеза. В доступной нам литературе, однако, не имеется сообщений, в которых были бы отражены результаты детального изучения этой проблемы с использованием анализа частоты и характера резистентности микобактерий туберкулеза у больных с сочетанием туберкулеза и хронического алкоголизма по сравнению с больными туберкулезом легких, не страдающими алкоголизмом. Именно сравнительное изучение этих показателей лекарственной устойчивости микобактерий туберкулеза и явилось задачей настоящего исследования.
Из двух наиболее распространенных способов лабораторного определения лекарственной устойчивости — метода пропорций, определяющего удельный вес устойчивых микобактерий среди всей бактериальной популяции, и метода абсолютных концентраций, т. е. определения минимальной концентрации препаратов, подавляющих рост микобактерий туберкулеза, мы пользовались последним, который применяют в нашей стране достаточно широко с использованием соответствующих клинических критериев резистентности к каждому препарату.
Рост культуры микобактерий туберкулеза, выделенной от больного, на среде Левенштейна — Иенсена, содержащей концентрации туберкулостатиков, превышающих границы клинической резистентности, снижает эффективность химиотерапии и является одной из .основных причин неудач лечения. Имеющиеся в литературе данные о лекарственной устойчивости микобактерий туберкулеза среди бациллярных больных, страдающих алкоголизмом, немногочисленны и в основном ограничиваются лишь констатацией значительного удельного веса такой резистентности к препаратам среди указанного контингента больных.
Мы провели сравнительное изучение частоты и характера лекарственной устойчивости микобактерий туберкулеза у двух групп больных. Первую группу составили бактериовыделители, страдающие одновременно туберкулезом легких и хроническим алкоголизмом (326 чело-иск), вторую, контрольную — бактериовыделители, у которых не было хронического алкоголизма (237 человек).
Как видно из табл. 15, лекарственная устойчивость культуры микобактерий туберкулеза у больных первой группы выявлялась чаще (42,9%), чем второй (34,6%). Разница статистически достоверна (Р
В настоящее время проблема лекарственной устойчивости возбудителя туберкулеза приобрела глобальное значение, во многом определяя распространение, клиническое течение и прогноз исходов заболевания. Важным аспектом является значительная эпидемиологическая опасность, которую представляют для окружающих больные, выделяющие мультирезистентные штаммы микобактерии туберкулеза. Устойчивость к рифампицину, первичная или приобретенная, значительно повышает вероятность обострений и рецидивов, а резистентность к рифампицину и изониазиду является прогностическим признаком неэффективности лечения, поэтому комбинированная устойчивость к этим двум препаратам расценивается как мультирезистентность микобактерий туберкулеза. Эффективность лечения этой категории больных значительно ниже, чем пациентов, выделяющих лекарственно-чувствительные штаммы микобактерии туберкулеза. Эпидемиологическое значение туберкулеза с лекарственной устойчивостью, особенно с мультирезистентностью, заключается, прежде всего, в том, что больные представляют собой наиболее опасный источник туберкулезной инфекции, в значительной мере определяя уровень инвалидности и смертности от туберкулеза.
С учетом вышесказанного изучение особенностей клинического течения, эффективности лечения лекарственно-устойчивого туберкулеза и разработка мер профилактики лекарственной устойчивости микобактерий туберкулеза к противотуберкулезным препаратам приобретают важное значение.
Целью исследования явился анализ результатов лечения больных туберкулезом, выделяющих штаммы микобактерий туберкулеза с лекарственной устойчивостью к противотуберкулезным препаратам за 2003 г. среди контингентов бактериовыделителей, состоящих на учете в противотуберкулезных учреждениях республики и среди вновь выявленных пациентов, находившихся на лечении в НИИ пульмонологии и фтизиатрии МЗ РБ, а также разработка методологии профилактики лекарственно-устойчивых форм туберкулеза.
В соответствии с поставленной целью была изучена эффективность диспансерного наблюдения контингентов бактериовыделителей за 2003 г. по показателям абациллирования и летальности от туберкулеза (по данным учетно-отчетных форм № 33).
Как видно из рис. 1, частота абациллирования у бактериовыделителей с множественной лекарственной устойчивостью микобактерии туберкулеза к противотуберкулезным препаратам в Республике Беларусь почти в 4 раза ниже, чем у бактериовыделителей без множественной лекарственной устойчивости. Наиболее низкий показатель конверсии мокроты в Гомельской и Могилевской областях (4,7 и 7,5% соответственно); наиболее высокий — в г. Минске и Гродненской области (14,5 и 16,4% соответственно) несмотря на то, что эти показатели крайне низкие.
Как видно из рис. 2, летальность бактериовыделителей с множественной лекарственной устойчивостью микобактерий туберкулеза к противотуберкулезным препаратам из состоявших на диспансерном учете в 2003 г. в среднем по республике в 2,5 раза выше, чем бактериовыделителей без множественной лекарственной устойчивости. Наиболее неблагоприятная ситуация в Гомельской и Могилевской областях (33,9 и 28,6% соответственно), более благополучная — в г. Минске и Витебской области, где данные показатели составили 14,1 и 18,7% соответственно.
Параллельно на базе клиники НИИ пульмонологии и фтизиатрии МЗ РБ был проведен анализ результатов лечения 60 пациентов с впервые выявленным инфильтративным туберкулезом легких.
После получения результатов лекарственной чувствительности микобактерий туберкулеза к противотуберкулезным препаратам были выделены четыре группы. У 18 больных первой группы микобактерии туберкулеза были чувствительны к противотуберкулезным препаратам. У 20 пациентов второй группы была выявлена монорезистентность (устойчивость к изониазиду, рифампицину или стрептомицину). У 12 больных третьей группы отмечалась устойчивость микобактерий туберкулеза одновременно к двум и более препаратам (изониазиду — стрептомицину, рифампицину — стрептомицину, изониазиду — этамбутолу, изониазиду — стрептомицину — этамбутолу), т.е. полирезистентность. У 10 больных четвертой группы наблюдалась множественная лекарственная устойчивость (одновременная устойчивость к изониазиду и рифампицину с устойчивостью к другим противотуберкулезным препаратам или без таковой).
Полученные нами данные тесно коррелируют с анализом результатов лечения больныхтуберкулезом, выделяющих штаммы микобактерий туберкулеза с лекарственной устойчивостью к противотуберкулезным препаратам за 2003 г., среди контингентов бактериовыделителей, состоящих на учете в противотуберкулезных учреждениях республики.
Таким образом, наши данные свидетельствуют о том, что эффективность лечения больных туберкулезом с поли- и особенно множественной лекарственной устойчивостью микобактерий туберкулеза к противотуберкулезным препаратам очень низка по сравнению с таковой у лиц, выделяющих лекарственно-чувствительные и монорезистентные штаммы микобактерии.
В соответствии с поставленными задачами нами также были разработаны меры профилактики первичной и вторичной лекарственной устойчивости возбудителя туберкулеза.
Основные принципы профилактики лекарственной устойчивости:
- раннее выявление и начало лечения всех бактериовыделителей;
- адекватная стандартизированная и контролируемая химиотерапия всем впервые выявленным больным (в соответствии с приказом МЗ РБ № 106 от 04.07.02);
- наличие в противотуберкулезных учреждениях необходимых противотуберкулезных препаратов;
- проведение разъяснительной работы с пациентами о недопустимости прерывания основного курса лечения.
Мероприятия по ограничению распространения мульти- и полирезистентности микобактерии туберкулеза к противотуберкулезным препаратам:
Разработанные мероприятия позволят существенно снизить распространенность лекарственно-устойчивых форм туберкулеза и повысить эффективность его лечения, что даст экономию значительных финансовых средств. В целом это благоприятно отразится на показателях заболеваемости и смертности от туберкулеза в Республике Беларусь.

Что такое микобактерия туберкулёза

Именно Роберт Кох предложил алгоритм для идентификации вызывающих туберкулёз бацилл, получивший также его имя (триада Коха) и применяемый до сих пор. Суть алгоритма состоит в следующем:
- Из тканей больного пациента извлекаются бактерии.
- Из них выращивается чистая культура – колонии бактерий.
- Далее, для получения клинической картины болезни, происходит заражение здорового организма (лабораторные мыши).
Клетка МБТ состоит из:
- микрокапсулы, защищающей микобактерию от внешних воздействий и связанной с клеточной стенкой;
- клеточной стенки, которая обеспечивает клетке стабильность её формы и размера;
- гомогенной цитоплазмы и цитоплазматической мембраны;
- ядерной субстанции (собственно набор хромосом и плазмиды).

За свою тысячелетнюю историю бактерии приобрели различные механизмы защиты и приспособления к неблагоприятным для них внешним условиям.
Оптимальная для роста МБТ температура – 37 – 38°С. Размножаются они при температурном режиме от 29°С до 42°С. Однако, туберкулёзные палочки в состоянии сохранить свою жизнеспособность в условиях как очень низких, так и довольно высоких температур (н.п., при температуре в 80°С палочка является жизнеспособной ещё на протяжении 5 минут, при кипячении гибнет через 15 минут).
Наиболее комфортно бактерии чувствуют себя в сырых и тёмных условиях, на ярком солнце и при высокой температуре окружающей среды они прекращают интенсивное размножение и гибнут через полтора-два часа. Ультрафиолетовые лучи в состоянии уничтожить микобактерии за 2 – 3 минуты.
На протяжении многих месяцев МТБ в состоянии выжить, находясь вне живого организма. В водной среде они сохраняются около 150 дней, в пыли на улицах – до 10 дней, на книжных страницах до 3 месяцев. В высушенной форме микобактерии могут выживать в периоде до 3-х лет, а в замороженном состоянии их жизнеспособность может достигать и 30 лет.
В неблагоприятных для бактерии условиях, при лечении туберкулёза с помощью химиотерапии или при мощном иммунитете, палочка Коха быстро вырабатывает устойчивость к препаратам, может принять L -форму, способна сохраняться в таком состоянии целые десятилетия и вызывать противотуберкулёзный иммунитет. У пациентов, длительное время принимавших противотуберкулёзные препараты, бактерии могут принимать мелкие фильтрующиеся формы.

Практически любой орган или ткань человеческого организма, включая костные ткани, может быть подвержен заболеванию туберкулёзом. Более 90% всех случаев заболевания поражает органы дыхания. Наиболее часто из других внелегочных форм происходит поражение микобактериями мочеполовой системы, суставов, печени и почек.
Лабораторная диагностика и методы исследования материала на содержание микобактерий

При подозрении на туберкулёз внелегочных форм в качестве материала для лабораторного анализа также используют кусочки тканей органов, взятые при биопсии, пункциях и соскобах.
Если речь идёт о возможном заражении половой или мочевыделительной системы, на анализ берут мочу, собранную после ночного сна утром, как правило, это средняя порция мочи. У женщин для обследования на туберкулёз женских половых органов используют менструальную кровь, которую собирают с помощью колпачка Кафки.
В исследовании материала современная медицина применяет следующие методы:
- бактериологические;
- микроскопические;
- аллергологические;
- биологические;
- молекулярно – генетические и серологические методы (применяются достаточно редко).

Для обнаружения L -форм используется в большинстве случаев фазово-контрастная микроскопия.
Необходимо просмотреть не менее 100 полей зрения для вынесения положительного ответа при обнаружении mycobacterium tuberculosis , при этом следует указать число бактерий в каждом поле. Однако следует отметить, что наличие отрицательного результата при микроскопии не даёт гарантии полностью исключить диагноз туберкулёза.
Микроскопический метод анализа имеет определённые недостатки, к которым в первую очередь относится низкая чувствительность: mycobacterium tuberculosis обнаруживается только при присутствии не менее 50 – 100 тысяч микробов на 1 мл исследуемого материала. Этот метод не позволяет отличить mycobacterium tuberculosis от других видов mycobacterium , он также не в состоянии определить чувствительность микобактерий к определённым химиотерапевтическим препаратам.

Главный недостаток этого метода состоит в том, что получение конечных результатов требует определённых затрат времени (от 3 до 12 недель). На искусственных средах рост микобактерий наступает через 3 – 6 недель. У пациентов, проходящих курс химиотерапии, выделенные штаммы вырастают на ещё более поздних сроках (от 50 до 80 дней). На сегодня современной медициной испытаны и ускоренные методы выращивания культур mycobacterium tuberculosis по методу Прайса (на препаратах – мазках) и по методу посева на кровяной среде.
С помощью бактериологического метода можно определить не только вирулентность культуры, но и её чувствительность к различным медицинским препаратам.

При этом методе материал вводиться морским свинкам подкожно или в брюшную полость. Если в материале присутствуют вирулентные mycobacterium tuberculosis , то обычно через 10 – 12 дней на месте инъекции образуется уплотнение, которое переходит в незаживающую язву. На протяжении 2 – 4 месяцев развивается генерализованный туберкулёз и свинки погибают.
Ускоренный биологический метод заключается во введении материала в региональный лимфоузел морской свинки. Увеличенный узел вырезается на 8 – 10 день и исследуется на присутствие микобактерий туберкулёза в препаратах-отпечатках.
В связи, с распространением в последние годы изменённых и устойчивых микобактерий чувствительность этого метода заметно снизилась. На сегодняшний день метод применяется в крупных специализированных лабораториях и требует строгого соблюдения режима проведения.
К этому методу относятся широко применяемые кожные туберкулиновые пробы. Проба Манту предусматривает введение туберкулина в предплечье, даёт положительные, отрицательные и резко положительные реакции. У детей и взрослых вводится различная концентрация вещества.
При помощи пробы Манту определяется круг лиц для проведения ревакцинации. Положительная проба Манту не является обязательным признаком наличия заболевания.
Профилактика
Основной профилактикой распространения микобактерий и предотвращение заболевания туберкулёзом является вакцина БЦЖ (Бацилла Кальметта-Герена). Вакцину изготовляют из штамма ослабленной живой mycobacterium bovis (бычий вид туберкулёзной палочки). При отсутствии противопоказаний вакцинацию проводят новорождённым в роддоме на 5 – 7 день жизни. Ревакцинация проводится в возрасте 7, 12, 17 и 22 лет при отрицательном результате пробы Манту и при отсутствии противопоказаний.
Взрослым с целью выявления туберкулёза на ранних стадиях не реже 1 раза в год необходимо проходить флюорографию лёгких в поликлинике. При резких изменениях реакции Манту за год или в случаях контакта с инфицированным больным фтизиатр может предложить проведение курса профилактической химиотерапии.
Читайте также:
 использование дозы лекарства, ниже рекомендованной,
использование дозы лекарства, ниже рекомендованной, высокая скученность зараженных людей,
высокая скученность зараженных людей, Туберкулез с множественной лекарственной устойчивостью (МЛУ-ТБ). Эта форма диагностируется при устойчивости микобактерии к двум самым сильным противотуберкулезным химиопрепаратам первой линии – Изониазиду и Рифампицину, независимо от наличия или отсутствия устойчивости к другим препаратам этой группы.
Туберкулез с множественной лекарственной устойчивостью (МЛУ-ТБ). Эта форма диагностируется при устойчивости микобактерии к двум самым сильным противотуберкулезным химиопрепаратам первой линии – Изониазиду и Рифампицину, независимо от наличия или отсутствия устойчивости к другим препаратам этой группы. больным, ранее получавшим лечение по поводу туберкулеза,
больным, ранее получавшим лечение по поводу туберкулеза, инъекционные антибиотики продолжают вводить еще 6 месяцев после прекращения бактериовыделения,
инъекционные антибиотики продолжают вводить еще 6 месяцев после прекращения бактериовыделения,